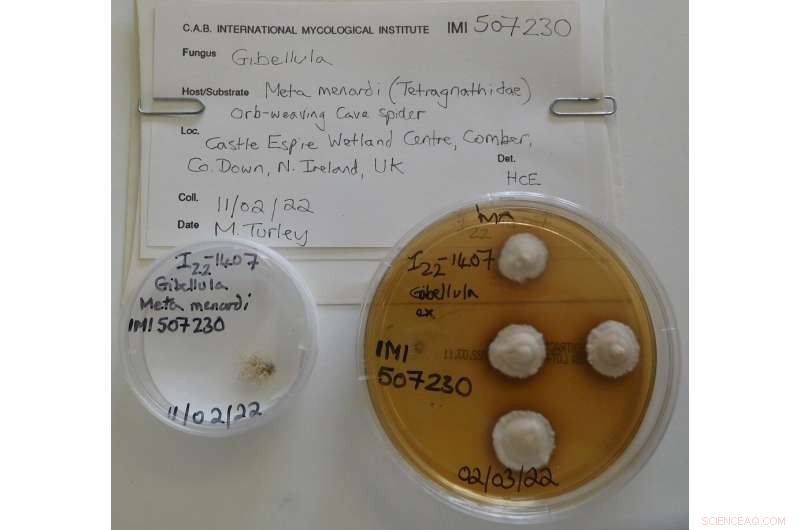
New Fungus Species Gibellula bang-bangus Discovered on Cave Spider Host

The new fungus Gibellula bang-bangus, on the orb-weaving cave spider Meta menardi, confirmed by CABI scientists. Credit: CABI
CABI has confirmed a new species of fungus after the BBC Springwatch show called on Dr. Harry Evans' expertise when the mysterious specimen was first discovered in a Victorian gunpowder store at Castle Espie wetland center in Northern Ireland.
The fungus, whose host is a cave spider, has been named Gibellula bang-bangus by viewers of the Springwatch program following Dr. Evans's initial investigations—based on the specimen's morphology—considered it to be a new species.
DNA analysis conducted by Dr. Alan Buddie and his team at CABI's laboratories in Egham, U.K., then confirmed that the fungus is indeed a new species of the spider-specific genus Gibellula.
Dr. Evans said, "Based on the DNA sequences taken from the culture isolate that I made—in the phylogenetic tree, the new species sits in a clade with two species from Asia: hence, the speculation about its Asian origin, made during the Springwatch program."
It was later suggested by Paul Stewart, Manager of Castle Espie, that the fungus could have arrived on gunpowder or packaging material in the 19th century (Down Recorder, 22 June 2022).
Dr Evans’s agar plate preparation as part of the analysis to confirm Gibellula bang-bangus as a new fungal species. Credit: CABI
However, the mystery has now been solved following the receipt of fresh specimens of the same fungus on the same spider species collected by a caving specialist, Tim Fogg, from two natural cave systems in Northern Ireland. His findings confirm that this is a native fungus specific to and pathogenic on an indigenous cave spider species: a host which also favors similar man-made habitats: such as culverts, tunnels and, in this case, a subterranean gunpowder store.